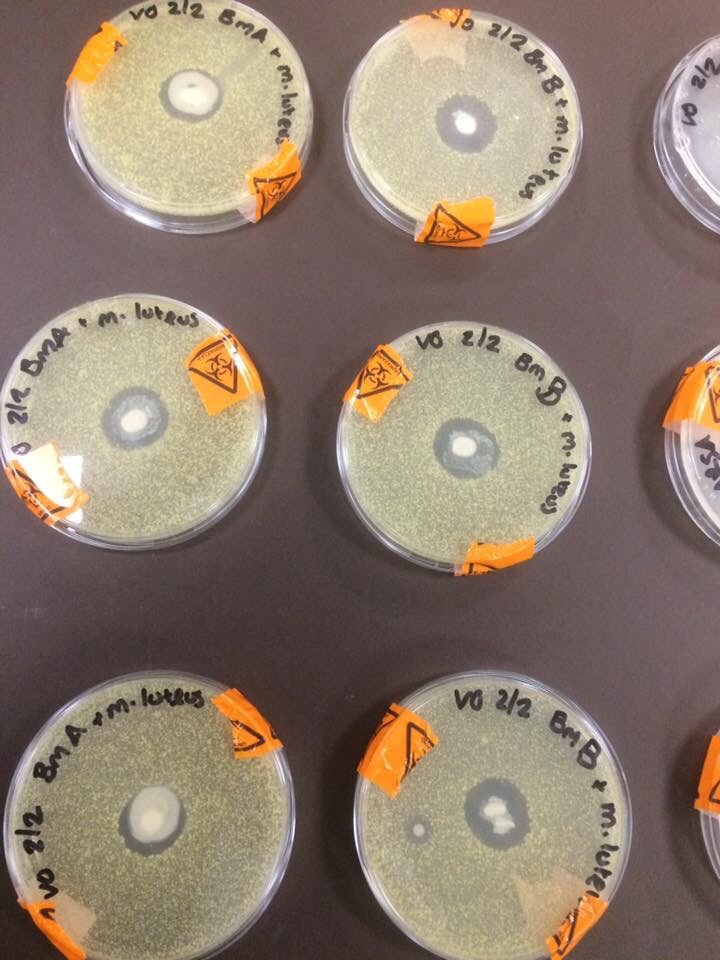

Fotografiju je objavila studentkinja biologije iz Engeske, a na njoj se vidi devet petijevih šolja sasvim kolonizovanih bakterijom M. Luteus, osim u samom centru svake, gde su kapljice majčinog mleka stvorile „odbrambeni zid“.
Viki Grin, kako se studentkinja zove, kaže da je dobre rezultate dobila i kada su u petrijevim šoljama bile Ešerihija Koli i MRSA (Zlatna stafilokoka otporna na Meticilin).
Oko 80% ćelija u majčinom mleku su makrofage, ćelije koje ubijaju bakterije, gljivice i viruse. Dojene bebe su zbog toga u znatnoj meri zaštićene od brojnih bolesti, uključujući upalu pluća, botulizam, bronhitis, stafilokokne infekcije, grip, upale uva i rubeole. Štaviše, majke prema potrebi proizvode antitela za bolesti sa kojima dođu u dodir i kojima su izložene i njihove bebe.
Uzorci mleka sa fotografije dolaze od majki petnaestomesečnog i trogodišnjeg deteta, što pokazuje da majčino mleko nastavlja da štiti dete i kada ono više nije beba. A budući da se imuni sistem sasvim razvija tek oko šeste godine, poželjno je da dete što duže bude dojeno i zaštićeno blagodetima majčinog mleka.
Izvor: Return to now